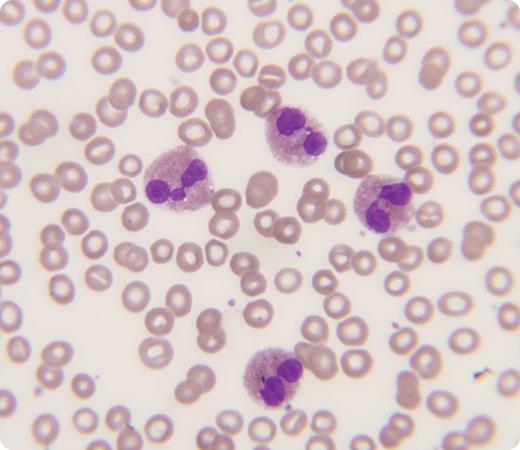
A 76-year-old female with chronic renal disease and dementia was admitted for acute chest pain. Physical examination showed no skin rash or wheezing. A CT scan for pulmonary embolism was positive and anticoagulation was started. Her blood tests showed white blood cells of 21.9 × 109/L, hemoglobin 10.2 g/dL, and platelets 308 × 109/L. The peripheral blood smear showed marked eosinophilia at 60% (see figure) and the red cells and platelets were normal. A bone marrow evaluation demonstrated 31% mature eosinophils without marrow dyspoietic changes. The FIP1L1-PDGFR fusion gene mutation was not present and the chromosomes showed a normal female karyotype. Two years later she was readmitted for worsening dementia and kidney failure. At that time laboratory testing showed normal white blood cells and no evidence of eosinophilia. / The presence of eosinophilia raises a number of clinical etiologic possibilities, including connective tissue disease, allergies, recent travel, parasitic infections, lymphomas, myeloproliferative disease, and drug reactions. None of these disorders had been present in this patient, but she had eosinophilia at a time when pulmonary embolization was present. An association between eosinophilia and thrombosis and/or embolization has been reported. Eosinophilia occurs in a number of pathophysiologic processes that involve the lung. The relationship between eosinophils and the clotting system is less well understood.

A 76-year-old female with chronic renal disease and dementia was admitted for acute chest pain. Physical examination showed no skin rash or wheezing. A CT scan for pulmonary embolism was positive and anticoagulation was started. Her blood tests showed white blood cells of 21.9 × 109/L, hemoglobin 10.2 g/dL, and platelets 308 × 109/L. The peripheral blood smear showed marked eosinophilia at 60% (see figure) and the red cells and platelets were normal. A bone marrow evaluation demonstrated 31% mature eosinophils without marrow dyspoietic changes. The FIP1L1-PDGFR fusion gene mutation was not present and the chromosomes showed a normal female karyotype. Two years later she was readmitted for worsening dementia and kidney failure. At that time laboratory testing showed normal white blood cells and no evidence of eosinophilia.
The presence of eosinophilia raises a number of clinical etiologic possibilities, including connective tissue disease, allergies, recent travel, parasitic infections, lymphomas, myeloproliferative disease, and drug reactions. None of these disorders had been present in this patient, but she had eosinophilia at a time when pulmonary embolization was present. An association between eosinophilia and thrombosis and/or embolization has been reported. Eosinophilia occurs in a number of pathophysiologic processes that involve the lung. The relationship between eosinophils and the clotting system is less well understood.
A 76-year-old female with chronic renal disease and dementia was admitted for acute chest pain. Physical examination showed no skin rash or wheezing. A CT scan for pulmonary embolism was positive and anticoagulation was started. Her blood tests showed white blood cells of 21.9 × 109/L, hemoglobin 10.2 g/dL, and platelets 308 × 109/L. The peripheral blood smear showed marked eosinophilia at 60% (see figure) and the red cells and platelets were normal. A bone marrow evaluation demonstrated 31% mature eosinophils without marrow dyspoietic changes. The FIP1L1-PDGFR fusion gene mutation was not present and the chromosomes showed a normal female karyotype. Two years later she was readmitted for worsening dementia and kidney failure. At that time laboratory testing showed normal white blood cells and no evidence of eosinophilia.
The presence of eosinophilia raises a number of clinical etiologic possibilities, including connective tissue disease, allergies, recent travel, parasitic infections, lymphomas, myeloproliferative disease, and drug reactions. None of these disorders had been present in this patient, but she had eosinophilia at a time when pulmonary embolization was present. An association between eosinophilia and thrombosis and/or embolization has been reported. Eosinophilia occurs in a number of pathophysiologic processes that involve the lung. The relationship between eosinophils and the clotting system is less well understood.
For additional images, visit the ASH IMAGE BANK, a reference and teaching tool that is continually updated with new atlas and case study images. For more information visit http://imagebank.hematology.org.